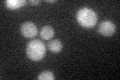
YDR229W

View description
Phospholipid-binding protein that interacts with both Ypt7p and Vps33p, may partially counteract the action of Vps33p and vice versa, localizes to the rim of the vacuole as cells approach stationary phase
Localization:
Intensity:
Fold change:
Significance:
-
C’ GFP library in SD

below threshold15.64 -
N' NOP1pr-GFP in SD

punctate,vacuole membrane67.5578 -
N' TEF2pr-mCherry in SD

punctate,vacuole membrane105.42 -
N' NATIVEpr-GFP in SD

punctate,vacuole membrane21.3702 -
N' TEF2pr-VC and Cyto-VN in SD

punctate52.4151 -
C’ GFP library in SD+DTT
cytosol15.771No -
C’ GFP library in SD+H2O2

cytosol16.61.06No -
C’ GFP library in Starvation Media

cytosol14.070.89No -
C’ GFP library on the background of Pup2-DaMP

below threshold -
C’ GFP library on the background of CCT mutant

below threshold16.92091.08096No
